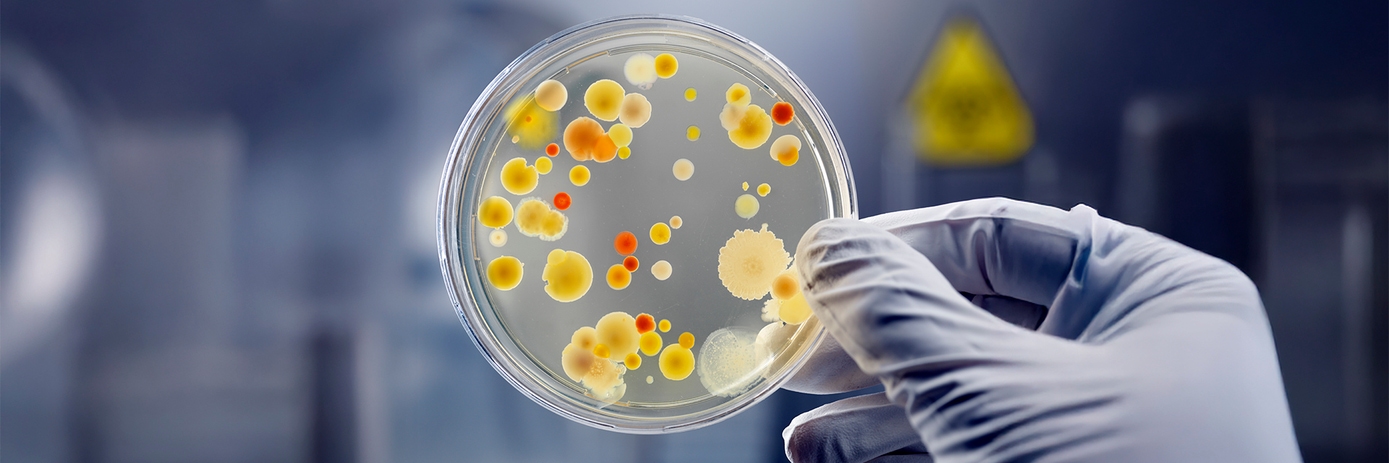
microbiology gated page hero

Automated nucleic acid extraction for diverse microbiology applications with chemagic systems
Are manual extraction processes holding your lab back?
Modern microbiology laboratories face mounting pressure: rising sample volumes, staffing shortages, and tight research timelines. Manual nucleic acid extraction creates operational bottlenecks that delay critical studies and compromise data consistency.
The cost of manual processes:
- Inconsistent extraction yields affecting downstream applications
- Human error and contamination risks during high-volume periods
- Limited flexibility to handle diverse sample types efficiently
- Excessive hands-on time preventing staff from higher-value work
Automation delivers measurable impact
Download this application note to discover how chemagic™ extraction systems are transforming microbiology workflows in laboratories worldwide.
What you'll learn:
✓ Proven performance across diverse organisms – Validated extraction from viral, bacterial, parasitic, and fungal organisms
✓ Unmatched sample versatility – Process different specimens (swabs, saliva, plasma, urine), environmental samples (wastewater, soil), and metagenomic material in a single workflow
✓ Platform flexibility validated – Customer-provided comparison demonstrates equivalent performance between chemagic 360 and chemagic Prepito™ systems
✓ NGS-ready quality – Highly intact nucleic acids compatible with next-generation and long-read sequencing applications
✓ Real contamination reduction – Magnetic bead movement (not liquid transfer) minimizes cross-contamination risks
To view the full content please answer a few questions
Download Resource
Automated nucleic acid extraction for diverse microbiology applications with chemagic systems




























